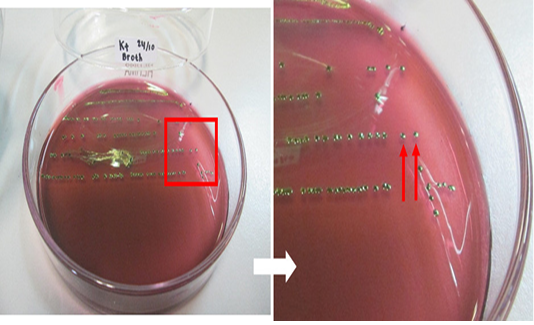
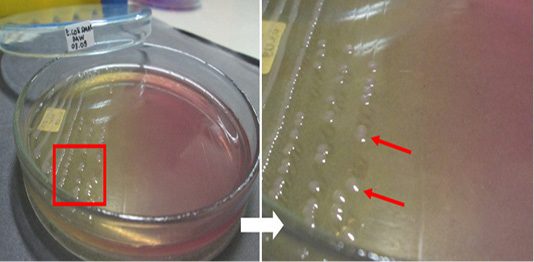

Journal of Animal Health and Production
Escherichia coli-positive control isolate culture on EMBA medium. The red arrow indicates the colonies.
Escherichia coli O157-positive control isolate culture on SMAC medium. The red arrow indicates the colonies.
Multiplex PCR optimization of E. coli O157:H7 with two target genes (fliC, 625 bp; rfbE, 317 bp). M = 100 bp DNA marker, 1 to 12 = annealing temperatures 50 to 61°C.
Multiplex PCR standardization E. coli O157:H7 with four target genes (eae, 375 bp; fliC, 625 bp; rfbE, 317 bp; stx2A, 553 bp). M = 100 bp DNA marker, 1 to 12 = annealing temperatures 50 to 61°C.
PCR results of samples. M = 100 bp DNA marker, K+ = positive control, K- = negative control, 1 = D1, 2 = D2, 3 = KR9, 4 = B6, 5 =B4, 6 =B3, 7 =B2, 8 = B7-2, 9 =B12-2, 10= B8-3, 11 = B14-3, 12 = B3-3, 13 = B12-3, and 14 = B16-2. Annealing temperature, 53 °C.
PCR results of samples. M = 100 bp DNA marker, K+ = positive control, K- = negative control, 1 =KR8-2, 2 = KR1-2, 3 = KR3-2, 4 = KR1-3, 5 = N2, 6 = D1-2, 7 = D2-2, 8 = D4-2, 9= D1-3, 10 = D4-3, 11 = N1-2, 12 = N2-2, 13 = N2-3, and 14 = L2-2. Annealing temperature 53 °C.